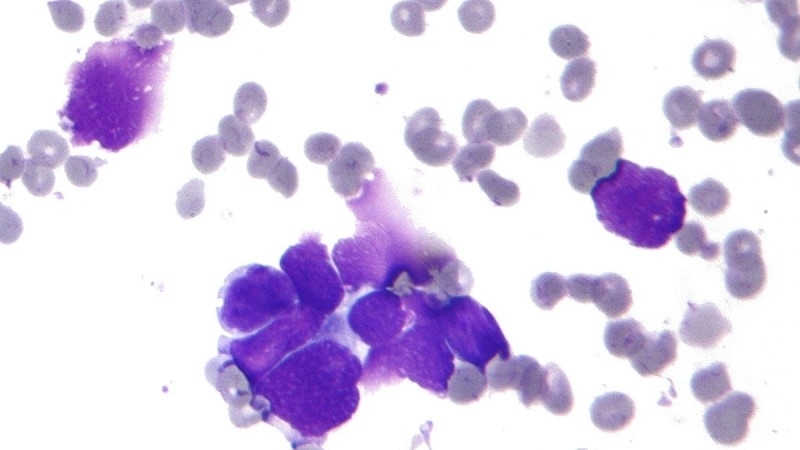

Москва, 19 июля. Врач-колопроктолог больницы №9 Санкт-Петербурга Анатолий Недозимованый назвал первые признаки рака толстой кишки.
Заболевание на ранних стадиях себя практически не проявляет, отмечает специалист. Но задолго до появления первых симптомов опухоль начинает необильно кровоточить. К признакам заболевания Недозимованый отнес кровотечения при дефекации разной степени выраженности, ощущение инородного тела в заднем проходе, слизь в стуле и расстройства дефекации.
«Даже эти первые симптомы — показатель уже давно развивающегося онкологического процесса», — цитирует врача портал «Доктор Питер».
Для раннего выявления болезни врач посоветовал ежегодно сдавать иммунохимический тест на скрытую кровь. В случае положительного результата следует делать ФКС, подчеркнул медик.
Ранее специалист Клиники кожных болезней Сеченовского университета, врач-дерматолог, онколог Екатерина Вертиева рассказала о неочевидных признаках рака кожи. Одним из них оказались рубцы на теле.